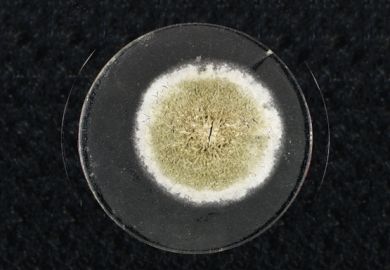

Matthew Reisz
Matthew Reisz was books editor as well as a features writer and reporter, until the end of 2021. He continues to write for Times Higher Education.
He grew up in London and studied Classics and French at Balliol College, Oxford. He has since worked as a journalist, editor, copywriter, ghost-writer and translator. He was, for several years, editor of the Jewish Quarterly and has also compiled and presented programmes for BBC Radio.
He was the 2009 winner of the National Education Journalist of the Year award, run by the Chartered Institute of Public Relations.